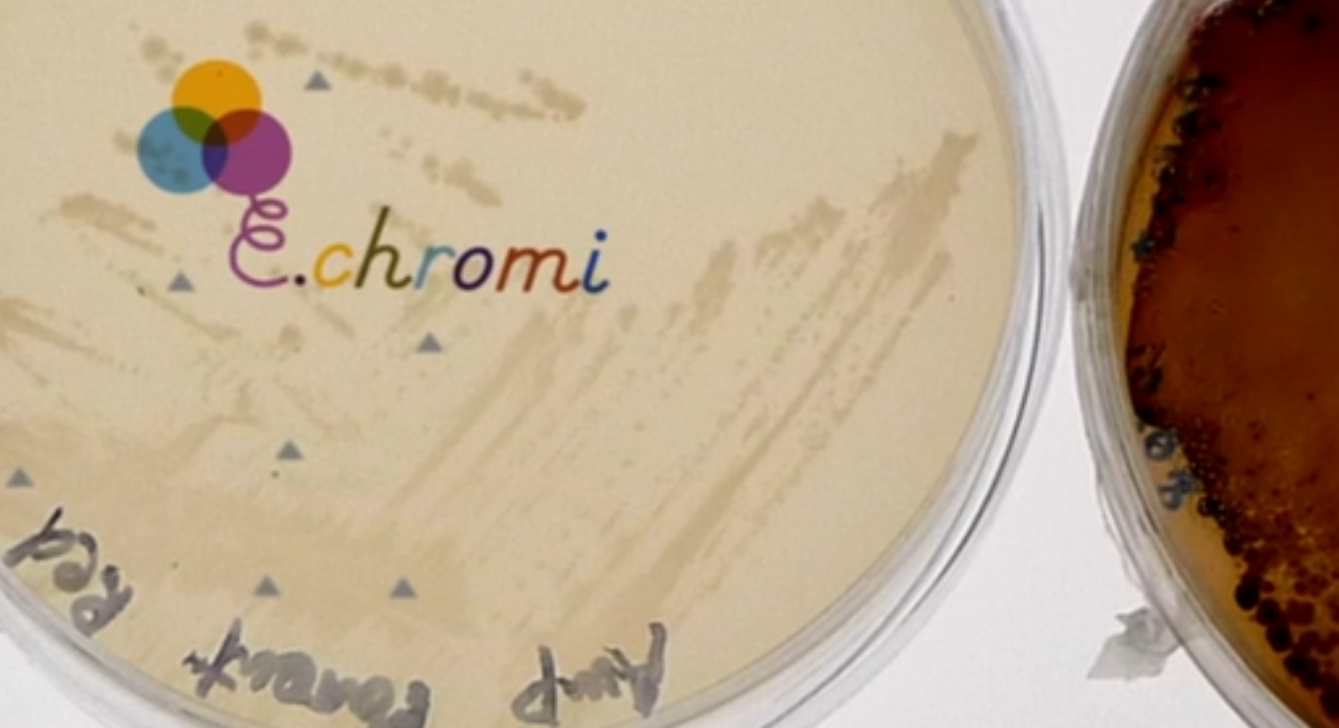

E. chromi
When science meets design exciting things happen. The latest comes from the brains at Cambridge who, while working in experimental…
When science meets design exciting things happen. The latest comes from the brains at Cambridge who, while working in experimental collaboration with designers created E. chromi - born from learning the ins and outs of synthetic biology and a foray into genetic engineering. Brace yourself for some technical talk. The process began by studying standardised sequences of DNA in a format known as ‘Bio bricks,’ and subsequently the students were able to engineer and design their own bricks by using genes copied from existing organisms. These were then inserted into E. Coli, they fine-tuned the bacteria’s bio sensors and programmed a colour detector to react to the sensor. Thus creating bacteria that can secrete colour visible to the eye. By improving bacterial bio-sensors – bacteria that can tell you the concentration of a pollutant in water – and plugging them into colour generators, they have managed to hot wire living organisms into living colour. The avenues of possibility for this are endless. From being able to colour feces blue due to the presence of an intestinal disease to responding to arsenic found in water, this is real live-saving stuff. As if this wasn't already totally mind-blowing, this project happened to bag them the International Genetically Engineered Machine Competition at MIT in 2009 and the video above explaining the process won the Bio:Fiction prize for best documentary. Cheers to our friends at Next Nature for the heads up on this craziness. We're excited to see how living colour can evolve, and hope to see it being rolled out in the real world soon. The implications are huge with possibility of it being used in disease monitoring, nutrition, food safety. Seeing science play with colour is something we know well with our Chromo calendar, check it out here.